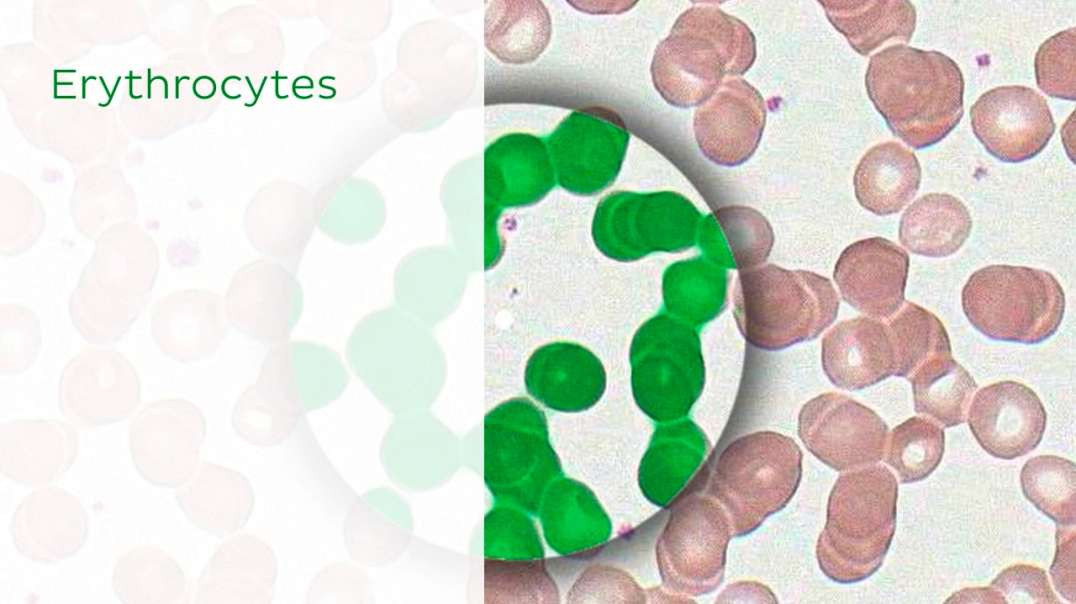
Bone marrow

Overview of the ethmoid bone
0
0
1 Views
Published on 24 Sep 2020 / In
Anatomi and Clinical Anatomy
Overview of the ethmoid bone kenhub
Show more
0 Comments
sort Sort By